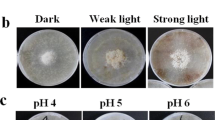

Abstract
Sclerotia are dense, hard tissue structures formed by asexual reproduction of fungal hyphae in adverse environmental conditions. Macrofungal sclerotia are used in medicinal materials, healthcare foods, and nutritional supplements because of their nutritional value and biologically active ingredients, which are attracting increasing attention. Over the past few decades, the influence of abiotic factors such as nutrition (e.g., carbon and nitrogen sources) and environmental conditions (e.g., temperature, pH), and of the local biotic community (e.g., concomitants) on the formation of macrofungal sclerotia has been studied. The molecular mechanisms controlling macrofungal sclerotia formation, including oxidative stress (reactive oxygen species), signal transduction (Ca2+ channels and mitogen-activated protein kinase pathways), and gene expression regulation (differential expression of important enzyme or structural protein genes), have also been revealed. At the end of this review, future research prospects in the field of biogenesis of macrofungal sclerotia are discussed.
Key points
• We describe factors that influence biogenesis of macrofungal sclerotia.
• We explain molecular mechanisms of sclerotial biogenesis.
• We discuss future directions of study of macrofungal sclerotia biogenesis.
Similar content being viewed by others
Avoid common mistakes on your manuscript.
Introduction
Sclerotia are hard, resting structures formed by the aggregation of fungal hyphae (Willetts and Bullock 1992; Smith et al. 2015). A sclerotium commonly includes a pseudoparenchymatous and melanized rind that encases a broad medulla of interwoven hyphae (Wong and Cheung 2008b). The sclerotia are formed from mycelia that continue to differentiate and tangle with each other to form a darker and harder mycelial tissue in nutrient-depleted and/or adverse environments (Song 2018; Lau and Abdullah 2017). They are morphologically variable, nutrient-rich structures with diameter ranging from < 1 mm to > 40 cm, and can remain dormant or quiescent when encountering adverse circumstances such as desiccation, microbial attack, or the long-term absence of a host (Smith et al. 2015; Lau and Abdullah 2017). It is generally accepted that sclerotia are able to survive conditions that are too severe for ordinary vegetative hyphae and spores (Willetts 1971). For example, harvested Pleurotus tuber-regium sclerotia have been demonstrated to remain viable or support successive fruiting over consecutive seasons (Isikhuemhen et al. 2000a; Fasidi and Ekuere 1992). Once the environmental conditions improve, sclerotia can germinate to form hyphae and/or fruitbodies or new sclerotia (Okhuoya and Etugo 1993; Song et al. 2014; Willetts and Bullock 1992; Wong and Cheung 2008a). Sclerotium-forming fungi are phylogenetically distributed among 85 genera in 20 orders of Ascomycota and Basidiomycota (Smith et al. 2015).
Macrofungi, also known as mushrooms, are defined to include ascomycetes and basidiomycetes with large, easily observed spore-bearing structures that form above or below ground (Mueller et al. 2007). Only a few macrofungi are known to form sclerotia, but these have a broad spectrum of pharmacological activity, such as antitumor, anticancer, antioxidant, immunoregulation, anti-inflammatory, and antimicrobial properties (Wong and Cheung 2008a, b; Yap et al. 2014a; Bandara et al. 2015; Sun et al. 2018; Tang et al. 2014; Kong et al. 2016; Wang et al. 2013; Nallathamby et al. 2018). Natural products from fungi are expected to play a key role in future discovery of effective, safer drugs (Silva et al. 2013). However, wild resources of macrofungal sclerotia are poor due to slow growth, insufficient protection, over-harvesting, and severe habitat loss (Wasser 2011). Moreover, artificial cultivation has suffered from low proliferation rate, unstable yield, and the scarcity of natural sclerotia to serve as seeds (Han et al. 2010). To meet the increasing demand for macrofungal sclerotia, in recent decades, researchers have studied the influence of some biotic and abiotic factors on the formation of sclerotia, and investigated the molecular mechanisms of their formation.
To help guide the efficient production and rational use of macrofungal sclerotia, in this review, we describe progress in research into the factors that influence biogenesis of macrofungal sclerotia, and the molecular mechanisms of the biogenesis. Future research areas are also discussed.
Factors affecting the biogenesis of macrofungal sclerotia
Various endogenous and exogenous factors, such as nutrition, environmental conditions, and the local biotic community, can affect sclerotia differentiation individually or in combination. The action of these factors can directly affect specific metabolic pathways, or indirectly affect physiological processes in the induction of sclerotia.
Nutrition and culture matrix affect biogenesis of macrofungal sclerotia
There have been numerous studies directed at analyzing the effect of nutrients and culture substrates on the initiation and development of macrofungal sclerotia. Findings from artificial cultivation studies have revealed that, in many cases, carbon sources and nitrogen sources are related to sclerotial formation (Kanwal and Reddy 2012; Liu and Guo 2009). In laboratory cultivation of Polyporus umbellatus (synonym Grifola umbellata), carbon sources, such as maltose, fructose, glucose, and glycerol, could be determining factors affecting sclerotial formation (Cheng et al. 2006; Xing et al. 2011); nitrogen sources could also influence this morphological transformation significantly; however, vitamins and mineral elements were found to have nothing to do with sclerotial formation (Liu and Guo 2009). In Morchella hybrida, d(+)xylose, l-glutamic acid, and l-ornithine HCl have been found to be the best carbon and nitrogen sources for sclerotia production (Prasher et al. 2017). The formation of macrofungal sclerotia using different nutrition sources may be related to the discrepant genetic backgrounds and metabolic pathways in different fungi (Liu and Guo 2009; Wong and Cheung 2008b). Nutritional factors can both stimulate and inhibit the formation of macrofungal sclerotia. Macrofungi generally do not form sclerotia in conditions suitable for mycelial growth. For example, it has been reported that the biogenesis of P. umbellatus and Morchella esculenta sclerotia can only occur on the nutrient-limited side of a split plate on which the other side contained noble nutrients (Yin et al. 2012; Amir et al. 1995). The effect of nutritional factors on the formation of macrofungal sclerotia may be caused by the transportation of critical nutrients in split culture. There is increasing evidence that certain nutrients, such as CuSO4·5H2O, could affect the formation of Boletus edulis sclerotia (Kaur and Prasher 2013). Moreover, the culture matrix can also affect the formation of macrofungal sclerotia. It has been demonstrated that Pleurotus tuber-regium sclerotia can grow on a wide range of lignocellulosic substrates such as ‘wawa’ (Triplochiton scleroxylon) sawdust, plantain (Musa sapiens) leaf, cotton waste, rice straw, corn cob, pumpkin, and banana leaves, but not water hyacinth (Eichhornia crassipes) or millet (Eleusine coracana) stalk (Apetorgbor et al. 2013; Fasidi and Ekuere 1992; Nwachukwu and Adedokun 2014). Pilot cultivation of Lignosus rhinocerotis was carried out with sawdust, paddy straw, and spent yeast at a ratio of 7.9:1:1 to a height of 100 mm in polypropylene bags. Sclerotia weighing between 80 and 120 g on a fresh-weight basis were formed 3–4 weeks after burying mature colonized substrate in the soil (Abdullah et al. 2013). In Inonotus obliquus, a substrate consisting of 44% birch (Betula platyphylla) sawdust, 42% corncob, 10% wheat bran, 2% soybean powder, 1% sucrose, 1% gypsum, and a water content of 65% supported the highest average yield of sclerotia (16.79 g/300 g dry substrate) (Han et al. 2010).
Environmental conditions affect biogenesis of macrofungal sclerotia
Environmental factors affect the formation of macrofungal sclerotia, including temperature, humidity, illumination, and aeration. Findings from studies in the laboratory and the field have revealed that low temperature contributes to the formation of Polyporus umbellatus sclerotia involving either the oxidative stress or antioxidant defense system (Xing et al. 2013b). G. umbellate can produce sclerotia at 18–25 °C in the laboratory, or in soil in the wild at 12.9–13.8 °C in November and 22.0–23.9 °C in August (Cheng et al. 2006; Choi et al. 2003). Morchella hybrida mycelia can grow and produce sclerotia best at 24 °C (Prasher et al. 2017). For Morchella rufobrunnea, inoculated medium can produce sclerotia after 2–3 weeks at 18–25 °C, higher than the fruit body formation temperature (Masaphy 2010).
It has been demonstrated that pH is important for sclerotial formation by P. umbellatus; sclerotia could be found in soil with pH from 3.98 to 5.75 (Kunca 2011; Choi et al. 2003), which could be characterized as very acidic to mildly acidic, but were not found in soils with limestone or dolomite mother rock, signifying that this macrofungi probably cannot grow in alkaline soils. Ophiocordyceps sinensis also preferred an acidic soil environment, while M. hybrida preferred a neutral pH environment.
Aeration is also an important environmental factor for sclerotial cultivation. For instance, Wolfiporia cocos sclerotia reached maximal yields when an air filter was used in mushroom culture bottles (Kubo et al. 2006). “Limited oxygen” was essential for the formation and growth of I. obliquus sclerotia, but sufficient oxygen was not conducive to sclerotial growth (Ji et al. 2016). Industrialization and automatic cultivation of O. sinensis was successfully realized by controlling temperature, light, pH, and so on, and no difference was observed from wild products, including in appearance, microstructure, and chemical components (Li et al. 2016a).
Concomitants affect biogenesis of macrofungal sclerotia
Some macrofungi, such as W. cocos and O. sinensis, have been reported to produce sclerotia only in the presence of particular host. W. cocos sclerotial formation is dependent on parasitism of the wood of Pinus species (Kubo et al. 2006). So far, the commercial production of W. cocos sclerotia relies on the existence of pine in the main production areas, and is limited by shortages in pine wood resources (Ma et al. 2018). Zhang et al. (2016) inferred that some special component(s) from Pinus species plants could induce the formation and development of the sclerotia, and that these unknown components induce the differential expression of genes involved in W. cocos sclerotial development. It has been proposed that the formation of O. sinensis sclerotia needs the presence of the host larvae whether in artificial or semi-natural conditions (Zhou et al. 2014). Birch species (Betula spp.) were selected as a model subject due to the clear preference of I. obliquus for this host and the fact that all pharmacological studies of the fungus were based on birch-associated material (Balandaykin and Zmitrovich 2015). Polyporus umbellatus sclerotia can establish symbiosis with Armillariella mellea in the wild. The rhizomorph of A. mellea adheres to and invades sclerotia of P. umbellatus; meanwhile, the sclerotia launch defense responses to fend off A. mellea invasion (Guo and Xu 1993). Other than A. mellea, other species of Armillaria fungi, such as A. sinapina, A. calvescens, and A. gallica, may have similar effects on the sclerotial development of P. umbellatus (Kikuchi and Yamaji 2010; Liu et al. 2015a).
Other factors
Interestingly, it was determined that macrofungal sclerotial biogenesis induced by the vaccination of the sclerotia of a revulsive strain is an effective method for the short-term formation of high-quality sclerotia in field cultivation (Choi et al. 2002; Xu et al. 2014). This phenomenon revealed that old sclerotia can stimulate the production of new sclerotia in appropriate conditions. In addition, macrofungal strains with different genetic backgrounds can yield sclerotia with different sizes and characteristics (Kobira et al. 2012; Isikhuemhen et al. 2000b). In I. obliquus, the sclerotium proliferation ability of mycelial inoculum declined as the generation number increased (Sun et al. 2011); this may have been caused by strain degradation and freshly inoculated hyphae needing more time to adapt to the medium.
Molecular mechanisms controlling biogenesis of macrofungal sclerotia
Oxidative stress response
The biogenesis of macrofungal sclerotia is triggered by biotic and/or abiotic stresses (Xing et al. 2011; Xing et al. 2013b; Ma et al. 2018; Xu et al. 2014). Exogenous factors such as temperature and infection and endogenous factors such as reactive oxygen species (ROS) can increase the internal oxidative stress and induce formation of macrofungal sclerotia (Liu et al. 2015b; Xing et al. 2013b). A convincing number of studies have established that sclerotial formation is associated with oxidative stress (Song et al. 2018; Georgiou et al. 2006; Patsoukis and Georgiou 2008; Xing et al. 2013b; Li et al. 2017). This theory was first proposed by Georgiou, who suggested that oxidative stress induced sclerotial differentiation in filamentous fungi (Georgiou 1997). The switch to a hyperoxidant state occurs via a transient increase in ROS levels beyond the cellular capability to neutralize them (Aguirre et al. 2005). It has been reported that enhanced ROS in the mycelial cell wall or around the organelle membranes might be important in triggering the differentiation of P. umbellatus sclerotia at low temperature (Xing et al. 2013b). The proteomes were analyzed in P. umbellatus sclerotia and hyphae in the initial, developmental, and mature phases, which showed that oxidative stress played an essential role in triggering sclerotial differentiation from hyphae (Li et al. 2017). Reactive oxygen radical scavengers could decrease intracellular oxidative stress and inhibit sclerotial formation in Morchella crassipes and P. umbellatus (He et al. 2014; Xing et al. 2013b). The Nox gene, a candidate for ROS generation, was upregulated (> 10-fold) in P. umbellatus sclerotia compared with mycelia (Xing et al. 2013a). Localized synthesis of ROS is important in establishing and maintaining polarized hyphal growth (Scott and Eaton 2008). The molecular mechanisms that control macrofungal metamorphosis might be homologous and analogous to the mechanisms, induced by oxidative stress, known in microsclerotium-forming plant pathogens such as Rhizoctonia solani (Patsoukis and Georgiou 2007, 2008), Metarhizium rileyi (Song et al. 2018), Sclerotium rolfsii (Ellil 1999), and Sclerotinia sclerotiorum (Patsoukis and Georgiou 2008; Osato et al. 2017). When a cellular hyperoxidative state surpasses the antioxidant capacity of the cell, there are three possible outcomes: (1) the cell compensates with a source of reducing power (nutrients) and returns to a stable state, thereby adapting to the more oxidizing condition; (2) the cell differentiates, insulating itself from environmental oxygen; or (3) when adaptation or differentiation cannot take place, the reduced internal medium equilibrates with the oxidizing external medium and the cell dies, which enables other cells to either adapt or differentiate (Fig. 1) (Aguirre et al. 2005). For fungal cells, the two latter conditions might induce sclerotial differentiation. Cell death or autolysis in a part of a cellular system or cell aggregate constitutes part of the cell differentiation process since it can provide substrates for growth or differentiation of other cells or parts of a cellular system (Georgiou and Petropoulou 2010). The exudates of macrofungal sclerotia containing proteins, fatty acids, ammonia, and various enzymes can usually be found during sclerotial biogenesis. Evidences shows that sclerotia have stronger antioxidant activity than mycelia in Morchella importuna (Liu et al. 2018b).The thick cell and melanized boundary observed in many sclerotia of macrofungi such as Pleurotus tuber-regium, I. obliquus, Polyporus umbellatus, and W. cocos can prevent oxygen and other substrates from permeating into cells.
A model for regulation of cell differentiation by ROS. A hyperoxidant state, a transient and unstable state in which generation of ROS surpasses the antioxidant capacity of the cell, regulates the transition between undifferentiated and differentiated states (Aguirre et al. 2005) (permitted by Elsevier)
Signal transduction in response to oxidative stress
The molecular mechanisms by which excessive ROS trigger the formation of new sclerotia have been elucidated. A critical feature of the fungal response to oxidative stress is rapid signaling of the new, stressful environment, which leads to a reprogramming of gene expression and expression of gene products required to buffer the otherwise lethal elevation in ROS (Moye-Rowley 2003). ROS have the potential to act directly on the fungal cell wall, plasma membrane receptors or ion channels, or diffuse across the membrane to activate internal signaling pathways (Scott and Eaton 2008). An important example is that of P. umbellatus Ca2+ channels, which may play an essential role in sclerotial formation. Different calcium channel blockers and calcium ionophores produced a similar physiological inhibition of the formation of P. umbellatus sclerotia (Liu and Guo 2010). Various signaling pathways could be recruited by macrofungal cells to deliver the oxidative stress signal to cell nuclei. Mitogen-activated protein kinase (MAPK) pathways are important signal transmitters from the cell surface to the inside of the nucleus. Transcriptomic, proteomic, and gene expression mode analysis of P. umbellatus sclerotia indicated that the oxidative stress signals were transmitted downstream through the MAPK pathways, regulating the glycosylation of cell wall proteins, thereby promoting the polarity of mycelium growth and a change in mycelial morphology to form sclerotia (Li et al. 2017; Liu et al. 2015b; Liu and Guo 2009; Song et al. 2014). By studying transcript profiles and assigning protein kinases (PKs) to orthologous groups, several orthologous PKs regulating MAPK signaling pathways were found to participate in the metamorphosis of W. cocos from mycelia to sclerotia (Wei et al. 2016). Another transcriptome analysis of sclerotial development in W. cocos revealed that MAPK-related genes, such as the Ras-GTPase gene, were highly expressed (Zhang et al. 2016). MAPK-related genes expression analysis of sclerotial development in M. importuna revealed that MAPK signaling pathways were activated and MAPK signaling probably initiated sclerotial formation (Liu et al. 2018a). In addition, the regulation of protein phosphorylation, the respiratory chain, the tricarboxylic acid cycle, glycolysis/gluconeogenesis, and secondary metabolite pathways in the formation of macrofungal sclerotia suggest the involvement of signal transduction and matter metabolism in sclerotial formation (Li et al. 2017; Yap et al. 2015; Zhu et al. 2018).
Regulation of gene expression
Gene expression is regulated by signal transduction from inside or outside the cell to the nucleus. Differentially expressed genes (DEGs) encoding enzymes or structural proteins have been identified between the mycelia and sclerotia in several sclerotium-forming macrofungi. Song et al. (2014) suggested that the sclerotia adapt to oxidative stress by upregulating oxidation-related and downregulating antioxidant-related gene expression. It has been confirmed that oxidation–reduction-related genes, such as those encoding cytochrome P450 and choline oxidase, are differentially expressed during macrofungal sclerotial differentiation from mycelia (Song et al. 2014; Wu et al. 2016; Yap et al. 2015). Comparative transcriptome analysis of Pleurotus tuber-regium sclerotia and mycelia indicated that 155 oxidation–reduction-related genes were significantly differentially expressed (our unpublished data). In the sclerotia of W. cocos, protein phosphatases (Wolco1|101289 and Wolco1|77624) orthologous to the type 2B protein phosphatase, which is involved in sclerotial development in S. sclerotiorum, were upregulated, indicating that they may be involved in sclerotial development in W. cocos (Harel et al. 2006; Zhu et al. 2018). It has been confirmed that carbohydrate active enzyme (CAZyme)-related genes, especially glycosyl hydrolases, are significantly upregulated or downregulated during the differentiation of Polyporus umbellatus, W. cocos, and O. sinensis sclerotia (Li et al. 2017; Wu et al. 2016; Zhang et al. 2016; Zhong et al. 2016). Additionally, some genes encoding desirable bioactive proteins, such as hydrophobins and cerato-platanins, might have roles in macrofungal sclerotial formation (Song et al. 2014; Yap et al. 2015). In M. conica, 13 specific DEG fragments were speculated to be functional genes associated with sclerotial formation (Chen et al. 2014). The result of gene expression regulation is, macroscopically, the formation of sclerotia, and, microscopically, the change of mycelial cell structure. For example, the cell wall of the macrofungal sclerotia is thicker than that in mycelia, which could be observed in P. umbellatus (Xing and Guo 2005), M. importuna (Liu et al. 2018b), and Pleurotus tuber-regium (Fig. 2).
Conclusions and future prospects
In recent years, macrofungal sclerotia have received increasing interest and there has been great progress in research in this field, embracing factors that influence sclerotial formation as well as their artificial production. The formation of macrofungal sclerotia is the product of internal genetic mechanisms and external factors. The sclerotium-forming macrofungal responses to oxidative stress were speculated to be regulated by nuclear localization control. Stress is transmitted to the nucleus via signal transduction. The result of the cell nucleus responding to stress is the differential expression of genes, thereby promoting the polarity of mycelial growth and mycelial morphological change to form sclerotia. It was reported that activity regulation via protein phosphorylation is one response to oxidative challenge (Moye-Rowley 2003). Whether there are other similar response mechanisms in macrofungi is worth exploring. At present, there are many unresolved but significant problems in understanding the complete molecular mechanisms participating in sclerotial formation; these may influence the sustainable development of macrofungal sclerotia. In addition, it was reported that differential gene expression will become apparent only after activating transcription factors are produced (Scott 2000). The identification and determination of roles of key transcription factors in macrofungal sclerotia biogenesis are worth exploring.
So far, genomes of several sclerotium-producing macrofungi, including L. rhinocerotis (Yap et al. 2014b), P. tuber-regium (Lam et al. 2018), Grifola frondosa (Li et al. 2018), W. cocos (Floudas et al. 2012), O. sinensis (Li et al. 2016b), Cordyceps militaris (Kramer and Nodwell 2017), and Cordyceps guangdongensis (Zhang et al. 2018) have been determined. Genome and transcriptome data, as well as advanced molecular tools, are available for the genetic engineering of sclerotium-producing macrofungi. Molecular tools, including classical genetic transformation and the clustered regularly interspaced short palindromic repeats (CRISPR) editing system, can provide valuable information for elaborating the process of macrofungal sclerotia formation (Chen et al. 2018; Liu et al. 2018a; Sugano et al. 2017; Sun et al. 2015; Yap et al. 2017). Future studies might also focus on the identification and functional characterization of DEGs during macrofungal sclerotial formation.
References
Abdullah N, Haimi MZD, Lau BF, Annuar MSM (2013) Domestication of a wild medicinal sclerotial mushroom, Lignosus rhinocerotis (Cooke) Ryvarden. Ind Crop Prod 47:256–261
Aguirre J, Ríos-Momberg M, Hewitt D, Hansberg W (2005) Reactive oxygen species and development in microbial eukaryotes. Trends Microbiol 13:111–118
Amir R, Steudle E, Levanon D, Hadar Y, Chet I (1995) Turgor changes in Morchella esculenta during translocation and sclerotial formation. Exp Mycol 19:129–136
Apetorgbor AK, Dzomeku M, Apetorgbor MM (2013) Growth factors and cultivation of Pleurotus tuber-regium on selected plant wastes. Int Food Res J 20:3387–3393
Balandaykin ME, Zmitrovich IV (2015) Review on Chaga medicinal mushroom, Inonotus obliquus (higher basidiomycetes): realm of medicinal applications and approaches on estimating its resource potential. Int J Med Mushrooms 17:95–104
Bandara AR, Rapior S, Bhat DJ, Kakumyan P, Chamyuang S, Xu J, Hyde KD (2015) Polyporus umbellatus, an edible-medicinal cultivated mushroom with multiple developed health-care products as food, medicine and cosmetics: a review. Cryptogamie Mycol 36:3–42
Chen BX, Wei T, Ye ZW, Yun F, Kang LZ, Tang HB, Guo LQ, Lin JF (2018) Efficient CRISPR-Cas9 gene disruption system in edible-medicinal mushroom Cordyceps militaris. Front Microbiol 9:1157
Chen LJ, Chai HM, Chen WM, Huang XQ, Zhao YC (2014) Gene expressing difference in sclerotial formation of Morchella conica. Indian J Microbiol 54:274–283
Cheng XH, Guo SX, Wang CL (2006) Factors influencing formation of sclerotia in Grifola umbellate (Pers.) Pilát under artificial conditions. J Integr Plant Biol 48:1312–1317
Choi KD, Kwon JK, Shim JO, Lee SS, Lee TS, Lee MW (2002) Sclerotial development of Grifola umbellate. Mycobiology 30:65–69
Choi KD, Lee KT, Shim JO, Lee YS, Lee TS, Lee SS, Guo SX, Lee MW (2003) A new method for cultivation of sclerotium of Grifola umbellate. Mycobiology 31:105–112
Ellil AHAA (1999) Oxidative stress in relation to lipid peroxidation, sclerotial development and melanin production by Sclerotium rolfsii. J Phytopathol 147:561–566
Fasidi IO, Ekuere UU (1992) Studies on Pleurotus tuber-regium (fries) singer: cultivation, proximate composition and mineral contents of sclerotia. Food Chem 48:255–258
Floudas D, Binder M, Riley R, Barry K, Blanchette RA, Henrissat B, Martínez AT, Otillar R, Spatafora JW, Yadav JS, Aerts A, Benoit I, Boyd A, Carlson A, Copeland A, Coutinho PM, de Vries RP, Ferreira P, Findley K, Foster B, Gaskell J, Glotzer D, Górecki P, Heitman J, Hesse C, Hori C, Igarashi K, Jurgens JA, Kallen N, Kersten P, Kohler A, Kües U, Kumar TK, Kuo A, LaButti K, Larrondo LF, Lindquist E, Ling A, Lombard V, Lucas S, Lundell T, Martin R, McLaughlin DJ, Morgenstern I, Morin E, Murat C, Nagy LG, Nolan M, Ohm RA, Patyshakuliyeva A, Rokas A, Ruiz-Dueñas FJ, Sabat G, Salamov A, Samejima M, Schmutz J, Slot JC, St John F, Stenlid J, Sun H, Sun S, Syed K, Tsang A, Wiebenga A, Young D, Pisabarro A, Eastwood DC, Martin F, Cullen D, Grigoriev IV, Hibbett DS (2012) The paleozoic origin of enzymatic lignin decomposition reconstructed from 31 fungal genomes. Science 336:1715–1719
Georgiou CD (1997) Lipid peroxidation in Sclerotium rolfsii: a new look into the mechanism of sclerotial biogenesis in fungi. Mycol Res 101:460–464
Georgiou CD, Patsoukis N, Papapostolou L, Zervoudakis G (2006) Sclerotial metamorphosis in filamentous fungi is induced by oxidative stress. Integr Comp Biol 46:691–712
Georgiou CD, Petropoulou KP (2010) Effect of the antioxidant ascorbic acid on sclerotial differentiation in Rhizoctonia solani. Plant Pathol 50:594–600
Guo SX, Xu JT (1993) Genesis and function of defense structure of sclerotia of Grifola umbellata after Armillariella mellea infection. Mycosystema 12:283–288 (in Chinese with an English abstract)
Han Z, Zhang J, Liu J, Dai X, Kong X, Ma Q, Zhang P (2010) Artificial cultivation of Inonotus obliquus. Acta Edulis Fungi 17:35–38
Harel A, Bercovich S, Yarden O (2006) Calcineurin is required for sclerotial development and pathogenicity of Sclerotinia sclerotiorum in an oxalic acid-independent manner. Mol Plant-Microbe Interact 19:682–693
He P, Liu W, Cai Y, Ma B, Chen L, Wu X (2014) Effects of oxidative stress on mycelial growth and sclerotial metamorphosis of Morchella crassipes. Hubei Agric Sci 53:3085–3089 (in Chinese with an English abstract)
Isikhuemhen OS, Moncalvo JM, Nerud F, Vilgalys R (2000a) Mating compatibility and phylogeography in Pleurotus tuberregium. Mycol Res 104:732–737
Isikhuemhen OS, Nerud F, Vilgalys R (2000b) Cultivation studies on wild and hybrid strains of Pleurotus tuberregium (Fr.) Sing. on wheat straw substrate. World J Microbiol Biotechnol 16:431–435
Ji H, Chen WJ, Ma YL, Han T, Huo H (2016) Study on domestication and cultivation of wild Inonotus obliquus strain JS-1. North Horticulture 2:229–232 (in Chinese with an English abstract)
Kanwal HK, Reddy MS (2012) The effect of carbon and nitrogen sources on the formation of sclerotia in Morchella spp. Ann Microbiol 62:165–168
Kaur S, Prasher IB (2013) Copper accumulation & carpophoroids/sclerotial bodies formation at elevated copper level in Boletus edulis Bull. ex Fr. Int J Sci Res 4:182–185
Kikuchi G, Yamaji H (2010) Identification of Armillaria species associated with Polyporus umbellatus using ITS sequences of nuclear ribosomal DNA. Mycoscience 51:366–372
Kobira S, Atsumi T, Kakiuchi N, Mikage M (2012) Difference in cultivation characteristics and genetic polymorphism between Chinese and Japanese strains of Wolfiporia cocos Ryvarden et Gilbertson (Poria cocos Wolf). J Nat Med 66:493–499
Kong BH, Tan NH, Fung SY, Pailoor J, Tan CS, Ng ST (2016) Nutritional composition, antioxidant properties, and toxicology evaluation of the sclerotium of Tiger Milk mushroom Lignosus tigris cultivar E. Nutr Res 36:174–183
Kramer GJ, Nodwell JR (2017) Chromosome level assembly and secondary metabolite potential of the parasitic fungus Cordyceps militaris. BMC Genomics 18:912
Kubo T, Terabayashi S, Takeda S, Sasaki H, Aburada M, Miyamoto K (2006) Indoor cultivation and cultural characteristics of Wolfiporia cocos sclerotia using mushroom culture bottles. Biol Pharm Bull 29:1191–1196
Kunca V (2011) Ecology and incidence of Polyporus umbellatus in Slovakia. Czech Mycol 63:39–53
Lam KL, Kaiwei S, Xiyang W, Tang S, Xiaohui S, Kwan HS, Cheung PCK (2018) The diploid genome of the only sclerotia-forming wild-type species in the genus Pleurotus– Pleurotus tuber-regium—provides insights into the mechanism of its biomass conversion from lignocellulose substrates. J Biotechnol 283:22–27
Lau BF, Abdullah N (2017) Sclerotium-forming mushrooms as an emerging source of medicinals: current perspectives. In: Petre M (ed) Mushroom biotechnology: developments and applications. Elsevier, San Diego, pp 111–136
Li B, Tian X, Wang C, Zeng X, Xing Y, Ling H, Yin Q, Tian L, Meng Z, Zhang J, Guo S (2017) SWATH label-free proteomics analyses revealed the roles of oxidative stress and antioxidant defensing system in sclerotia formation of Polyporus umbellatus. Sci Rep 7:41283
Li H, Wu S, Ma X, Chen W, Zhang J, Duan S, Gao Y, Kui L, Huang W, Wu P, Shi R, Li Y, Wang Y, Li J, Guo X, Luo X, Li Q, Xiong C, Liu H, Gui M, Sheng J, Dong Y (2018) The genome sequences of 90 mushrooms. Sci Rep 8:9982
Li WJ, Dong CH, Liu XZ, Li QP, Xia JM, Liang L (2016a) Research advances in artificial cultivation of Chinese cordyceps. Mycosystema 35:375–387 (in Chinese with an English abstract)
Li Y, Hsiang T, Yang RH, Hu XD, Wang K, Wang WJ, Wang XL, Jiao L, Yao YJ (2016b) Comparison of different sequencing and assembly strategies for a repeat-rich fungal genome, Ophiocordyceps sinensis. J Microbiol Methods 128:1–6
Liu YY, Guo SX (2009) Nutritional factors determining sclerotial formation of Polyporus umbellatus. Lett Appl Microbiol 49:283–288
Liu YY, Guo SX (2010) Involvement of Ca2+ channel signalling in sclerotial formation of Polyporus umbellatus. Mycopathologia 169:139–150
Liu MM, Xing YM, Zeng X, Zhang DW, Guo SX (2015a) Genetic diversity of Armillaria spp. symbiotic with Polyporus umbellatus in China. Biochem Syst Ecol 61:524–530
Liu MM, Xing YM, Zhang DW, Guo SX (2015b) Transcriptome analysis of genes involved in defence response in Polyporus umbellatus with Armillaria mellea infection. Sci Rep 5:16075
Liu DM, Zhu HY, Chen Y, Zheng LS, Chen L, Ma AM (2018a) Agrobacterium tumefaciens-mediated transformation of the king tuber medicinal mushroom Lentinus tuber-regium (Agaricomycetes). Int J Med Mushrooms 20:791–796
Liu Q, Zhao Z, Dong H, Dong C (2018b) Reactive oxygen species induce sclerotial formation in Morchella importuna. Appl Microbiol Biotechnol 102:7997–8009
Ma F, Chen P, Zhou Q, Sun S (2018) Evaluation on intrinsic quality of Wolfiporia cocos influenced by cultivation methods by a multi-step IR macro-fingerprinting technique. J Mol Struct 1165:23–27
Masaphy S (2010) Biotechnology of morel mushrooms: successful fruiting body formation and development in a soilless system. Biotechnol Lett 32:1523–1527
Moye-Rowley WS (2003) Regulation of the transcriptional response to oxidative stress in fungi: similarities and differences. Eukaryot Cell 2:381–389
Mueller GM, Schmit JP, Leacock PR, Buyck B, Cifuentes J, Desjardin DE, Halling RE, Hjortstam K, Iturriaga T, Larsson KH, Lodge DJ, May TW, Minter D, Rajchenberg M, Redhead SA, Ryvarden L, Trappe JM, Watling R, Wu Q (2007) Global diversity and distribution of macrofungi. Biodivers Conserv 16:37–48
Nallathamby N, Phan CW, Seow SLS, Baskaran A, Lakshmanan H, Malek SNA, Sabaratnam V (2018) A status review of the bioactive activities of tiger milk mushroom Lignosus rhinocerotis (Cooke) Ryvarden. Front Pharmacol 8:998
Nwachukwu PC, Adedokun OM (2014) King tuber mushroom: bioconversion of fluted pumpkin, sawdust and paper. African J Plant Sci 8:164–166
Okhuoya JA, Etugo JE (1993) Studies of the cultivation of Pleurotus tuber-regium (FR) sing. An edible mushroom. Bioresource Technol 44:1–3
Osato T, Park P, Ikeda K (2017) Cytological analysis of the effect of reactive oxygen species on sclerotia formation in Sclerotinia minor. Fungal Biol 121:127–136
Patsoukis N, Georgiou CD (2007) Effect of thiol redox state modulators on oxidative stress and sclerotial differentiation of the phytopathogenic fungus Rhizoctonia solani. Arch Microbiol 188:225–233
Patsoukis N, Georgiou CD (2008) Thiol redox state and oxidative stress affect sclerotial differentiation of the phytopathogenic fungi Sclerotium rolfsii and Sclerotinia sclerotiorum. J Appl Microbiol 104:42–50
Prasher IB, Sharma M, Chandel VC, Chander H (2017) Effect of physical factors, carbon and nitrogen sources on the growth and sclerotial production in Morchella hybrida (Sow.) Pers. J Biol Chem Chron 3:20–27
Scott B, Eaton CJ (2008) Role of reactive oxygen species in fungal cellular differentiations. Curr Opin Microbiol 11:488–493
Scott MP (2000) Development: the natural history of genes. Cell 100:27–40
Silva DDD, Rapior S, Sudarman E, Stadler M, Xu J, Alias A (2013) Bioactive metabolites from macrofungi: ethnopharmacology, biological activities and chemistry. Fungal Divers 62:1–40
Smith ME, Henkel TW, Rollins JA (2015) How many fungi make sclerotia? Fungal Ecol 13:211–220
Song Z (2018) Fungal microsclerotia development: essential prerequisites, influencing factors, and molecular mechanism. Appl Microbiol Biotehnol 102:9873–9880
Song C, Liu M, Xing Y, Guo S (2014) ESTs analysis of putative genes engaged in Polyporus umbellatus sclerotial development. Int J Mol Sci 15:15951–15962
Song Z, Yin Y, Lin Y, Du F, Ren G, Wang Z (2018) The bZIP transcriptional factor activator protein-1 regulates Metarhizium rileyi morphology and mediates microsclerotia formation. Appl Microbiol Biotechnol 102:4577–4588
Sugano SS, Suzuki H, Shimokita E, Chiba H, Noji S, Osakabe Y, Osakabe K (2017) Genome editing in the mushroom-forming basidiomycete Coprinopsis cinerea, optimized by a high-throughput transformation system. Sci Rep 7:1260
Sun Q, Wei E, Zhao J, Song J, Peng F, Zhang S, Zheng Y, Chen P, Zhu W (2015) An efficient PEG/CaCl2-mediated transformation approach for the medicinal fungus Wolfiporia cocos. J Microbiol Biotechnol 25:1528–1531
Sun XY, Zhu HY, Wang YY, Liu DM, Ma AM (2018) Research progress in the biological activities in macrofungal sclerotia. Sci Tech Food Ind 39:334–338 (in Chinese with an English abstract)
Sun Y, Yin T, Chen XH, Zhang G, Curtis PB, Lu ZH, Jiang JH (2011) In vitro antitumor activity and structure characterization of ethanol extracts from wild and cultivated Chaga medicinal mushroom, Inonotus obliquus (Pers.:Fr.) Pilát (Aphyllophoromycetideae). Int J Med Mushrooms 13:121–130
Tang J, Nie J, Li D, Zhu W, Zhang S, Ma F, Sun Q, Song J, Zheng Y, Chen P (2014) Characterization and antioxidant activities of degraded polysaccharides from Poria cocos sclerotium. Carbohyd Polym 105:121–126
Wang YZ, Zhang J, Zhao YL, Li T, Shen T, Li JQ, Li WY, Liu HG (2013) Mycology, cultivation, traditional uses, phytochemistry and pharmacology of Wolfiporia cocos (Schwein.) Ryvarden et Gilb.: a review. J Ethnopharmacol 147:265–276
Wasser SP (2011) Current findings, future trends, and unsolved problems in studies of medicinal mushrooms. Appl Microbiol Biotechnol 89:1323–1332
Wei W, Shu S, Zhu W, Xiong Y, Peng F (2016) The kinome of edible and medicinal fungus Wolfiporia cocos. Front Microbiol 7:1495
Willetts HJ (1971) The survival of fungal sclerotia under adverse environmental conditions. Biol Rev 46:387–407
Willetts HJ, Bullock S (1992) Developmental biology of sclerotia. Mycol Res 96:801–816
Wong KH, Cheung PCK (2008a) Sclerotia: emerging functional food derived from mushrooms. In: Cheung PCK (ed) Mushrooms as functional foods. John Wiley & Sons, Hoboken, pp 111–146
Wong KH, Cheung PCK (2008b) Sclerotium of culinary-medicinal king tuber oyster mushroom, Pleurotus tuberregium (Fr.) singer (Agaricomycetideae): its cultivation, biochemical composition, and biopharmacological effects (review). Int J Med Mushrooms 10:303–313
Wu Y, Zhu W, Wei W, Zhao X, Wang Q, Zeng W, Zheng Y, Chen P, Zhang S (2016) De novo assembly and transcriptome analysis of sclerotial development in Wolfiporia cocos. Gene 588:149–155
Xing X, Guo S (2005) Morphological characteristics of sclerotia formed from hyphae of Grifola umbellata under artificial conditions. Mycopathologia 159:583–590
Xing YM, Chen J, Lv YL, Liang HQ, Guo SX (2011) Determination of optimal carbon source and pH value for sclerotial formation of Polyporus umbellatus under artificial conditions. Mycol Prog 10:121–125
Xing YM, Chen J, Song C, Liu YY, Guo SX, Wang CL (2013a) Nox gene expression and cytochemical localization of hydrogen peroxide in Polyporus umbellatus sclerotial formation. Int J Mol Sci 14:22967–22981
Xing YM, Zhang LC, Liang HQ, Lv J, Song C, Guo SX, Wang CL, Lee TS, Lee MW (2013b) Sclerotial formation of Polyporus umbellatus by low temperature treatment under artificial conditions. PLoS One 8:e56190
Xu Z, Tang W, Xiong B, Wang K, Bian Y (2014) Effect of revulsive cultivation on the yield and quality of newly formed sclerotia in medicinal Wolfiporia cocos. J Nat Med 68:576–585
Yap HYY, Aziz AA, Fung SY, Ng ST, Tan CS, Tan NH (2014a) Energy and nutritional composition of Tiger Milk mushroom (Lignosus tigris Chon S. Tan) sclerotia and the antioxidant activity of its extracts. Int J Med Sci 11:602–607
Yap HYY, Chooi YH, Firdaus-Raih M, Fung SY, Ng ST, Tan CS, Tan NH (2014b) The genome of the Tiger Milk mushroom, Lignosus rhinocerotis, provides insights into the genetic basis of its medicinal properties. BMC Genomics 15:635
Yap HYY, Chooi YH, Fung ST, Ng ST, Tan CS, Tan NH (2015) Transcriptome analysis revealed highly expressed genes encoding secondary metabolite pathways and small cysteine-rich proteins in the sclerotium of Lignosus rhinocerotis. PLoS One 10:e0143549
Yap HYY, Muria-Gonzalez MJ, Kong BH, Stubbs KA, Tan CS, Ng ST, Tan NH, Solomon PS, Fung SY, Chooi YH (2017) Heterologous expression of cytotoxic sesquiterpenoids from the medicinal mushroom Lignosus rhinocerotis in yeast. Microb Cell Factories 16:103
Yin WQ, Guo SX, Xing YM, Xing XK (2012) A new method to induce sclerotial differentiation in Polyporus umbellatus by split-plate culture. Mycol Prog 11:957–960
Zhang C, Deng W, Yan W, Li T (2018) Whole genome sequence of an edible and potential medicinal fungus, Cordyceps guangdongensis. G3-Genes Genom Genet 8:1863–1870
Zhang S, Hu B, Wei W, Xiong Y, Zhu W, Peng F, Yu Y, Zheng Y, Chen P (2016) De novo analysis of Wolfiporia cocos transcriptome to reveal the differentially expressed carbohydrate-active enzymes (CAZymes) genes during the early stage of sclerotial growth. Front Microbiol 7:83
Zhong X, Gu L, Li SS, Kan XT, Zhang GR, Liu X (2016) Transcriptome analysis of Ophiocordyceps sinensis before and after infection of Thitarodes larvae. Fungal Biol 120:819–826
Zhou XW, Li LJ, Tian EW (2014) Advances in research of the artificial cultivation of Ophiocordyceps sinensis in China. Crit Rev Biotechnol 34:233–243
Zhu W, Wei W, Zhang S, Zheng Y, Chen P, Xu X (2018) The phosphatome of medicinal and edible fungus Wolfiporia cocos. Curr Microbiol 75:124–131
Acknowledgments
This research was supported by a grant from the National Natural Science Foundation of China (No. 31772375) to Aimin Ma.
Disclaimer
The views stated here are ours and ours only. We apologize if we failed to mention other significative research from other sclerotium-producing mushroom and if our interpretation of the data is not accepted by other researchers.
Author information
Authors and Affiliations
Contributions
All authors contributed to this study. XS and AM had the ideas for the article and performed the literature search and data analysis. XS wrote the manuscript. DL, YW, and AM critically reviewed the manuscript.
Corresponding author
Ethics declarations
Conflict of interest
The authors declare that they have no conflict of interest.
Ethical approval
This article does not contain any studies with human participants or animals performed by any of the authors.
Additional information
Publisher’s note
Springer Nature remains neutral with regard to jurisdictional claims in published maps and institutional affiliations.
Rights and permissions
About this article
Cite this article
Sun, X., Liu, D., Wang, Y. et al. Biogenesis of macrofungal sclerotia: influencing factors and molecular mechanisms. Appl Microbiol Biotechnol 104, 4227–4234 (2020). https://doi.org/10.1007/s00253-020-10545-8
Received:
Revised:
Accepted:
Published:
Issue Date:
DOI: https://doi.org/10.1007/s00253-020-10545-8